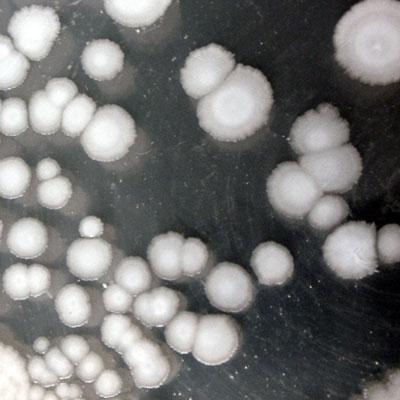

Press release
Global Bacillus Subtilis Market Report 2019 Companies included Bayer (Germany), BASF (Germany), Tonglu Huifeng (China), Kernel Bio-tech (China) and Others
Market Reports Company has recently published 7th edition of Bacillus Subtilis Market Report which covers historic data of year 2013 to 2018 along with a forecast till year 2026.For inquiry or free sample pages email us at: sales@marketreportscompany.com
The report provides a comprehensive view on the current state and future prospects of the market which analyzes different strategies for business growth. The global Bacillus Subtilis market was valued at USD xx Million in 2018 and is anticipated to show significant growth in the near future. In this report, the market can be classified into types, applications, and regions. The report also offers a detailed competitive analysis of all the major players who are active in this market.
Request report sample pages prior purchase@ http://marketreportscompany.com/contact.php
Report Coverage:
•Top Companies
Bayer (Germany)
BASF (Germany)
Tonglu Huifeng (China)
Kernel Bio-tech (China)
Wuhan Nature?s Favour (China)
Agrilife (US)
Real IPM (Kenya)
ECOT China (China)
Qunlin (China)
Others (Note: We cover all the Top players actively present in the market and you can also request to profile your competitor's data as a part of report customization without any additional cost)
•Bacillus Subtilis market segments by Type:
?100 Billion CFU/g
100-300 Billion CFU/g
?300 Billion CFU/g
Others
• Bacillus Subtilis market segments by Applications:
Feed Additives
Pesticide
Others
•Regions covered: (we can provide region/country specific report)
North America (USA, Canada and Mexico)
Europe (Germany, France, UK, Russia, Italy and Others)
Asia-Pacific (China, Japan, Korea, India, Southeast Asia and Others)
South America (Brazil, Argentina, Columbia and Others)
The Middle East and Africa (Saudi Arabia, UAE, Egypt, Nigeria, South Africa and Others)
(Note: We can provide country or region specific report on request; please contact us at sales@marketreportscompany.com )
Our reports are designed keeping in mind the need of all members across the value chain. However, if any
particular pointer needs to covered to meet your specific requirements, we can provide a customized
report. The below mentioned customization pointers are available for the report.
● Detailed Analysis for additional company profiles
● Specific Country Level breakdown by Application and type
● Additional Segment Analysis
● Others
The said report has been derived by findings drawn from thorough primary research and secondary research. The report covers complete quantitative and qualitative information by analyzing data collected by prominent players across key points in the industry’s value chain.
How helpful this report will be?
• In depth analysis on emerging regions, types & Application, and competitive landscape
• Key parameters which are driving market and restraining market growth.
• The report will help you understand Industry Dynamics, Market Size and Forecast, Market Entry
Strategy, Competitive Intelligence, Pricing Analysis, Consumer Insights, Procurement Intelligence,
Next-generation Technologies, etc.
Purchase Inquire before Buying @ http://marketreportscompany.com/contact.php
Table of Content:
(Request detailed TOC @sales@marketreportscompany.com)
Global Bacillus Subtilis Market Size, Status and Forecast 2026
1 Industry Overview of Global Bacillus Subtilis
2 Global Bacillus Subtilis Competition Analysis by Players
3 Company (Top Players) Profiles
4 Global Bacillus Subtilis Market Size by Type and Application (2013-2019)
5 Development Status and Outlook…
11 Market Forecast by Regions, Type and Application (2019-2026)
12 Global Bacillus Subtilis Market Dynamics
12.1 Global Bacillus Subtilis Industry News
12.2 Global Bacillus Subtilis Industry Development Challenges
12.3 Global Bacillus Subtilis Industry Development Opportunities (2019-2026)
13 Market Effect Factors Analysis
14 Global Bacillus Subtilis Market Forecast (2019-2026)
15 Research Finding/Conclusion
16 Appendix........................to receive complete Table of Content @ http://marketreportscompany.com/contact.php
What Does Report Include?
Historic Data: What was the Bacillus Subtilis Market data (Size, competition, company share, YoY growth rate, etc.) from 2013 to 2019.
Current Market Status: A comprehensive analysis of current market Size, trends, growth drivers, industry pitfalls, challenges and opportunities for players.
Market Forecast: Report will comment and provide details about market growth and forecast till the year 2025.
Customization: We can provide following things 1) On request more company profiles (competitors) 2) Data about a particular country or region 3) We will incorporate the same with no additional cost (Post conducting feasibility).
About us: http://marketreportscompany.com/about-us.php
Contact Us:
Jason Smith,
Sales Manager, Global Business Development,
Website: marketreportscompany.com
Email: jasonsmith@marketreportscompany.com
Phone: +1-312-376-8303
Address: 20 N State Street,
Chicago, Illinois, 60602
United States
This release was published on openPR.
Permanent link to this press release:
Copy
Please set a link in the press area of your homepage to this press release on openPR. openPR disclaims liability for any content contained in this release.
You can edit or delete your press release Global Bacillus Subtilis Market Report 2019 Companies included Bayer (Germany), BASF (Germany), Tonglu Huifeng (China), Kernel Bio-tech (China) and Others here
News-ID: 1617214 • Views: …
More Releases for China
China fund establishment, China fund management,china investment management
Pandacu China is a leading financial institution that specializes in providing fund establishment and management services for domestic and international investors looking to invest in China. The company was founded in 2015 by a team of experienced finance professionals with a deep understanding of the Chinese market and a strong network of contacts in the investment industry.
https://boomingfaucet.com/
China Fund Establishment Consultation
E-mail:nolan@pandacuads.com
Investing in China can be a complex and challenging process, and…
China Finance Advisor, China Debt Finance Corporation,China Investment Corporati …
Investment bank is a financial institution that helps companies and governments raise capital by underwriting and issuing securities, and also provides advice on mergers and acquisitions, strategic investments, and other financial matters. Investment banks typically have a team of professionals with expertise in various areas such as corporate finance, securities underwriting, sales and trading, and market research.
http://pandacuads.com/
China Investment Corporation
Email:nolan@pandacuads.com
Some of the main services provided by investment banks include:
Underwriting: Investment banks…
China Investment Bank, China Investment Consultant, China Investment Corporation …
Pandacu is a company that specializes in cross-border investment in China. The company was founded in china and has since grown to become one of the leading cross-border investment firms in China. Pandacu offers a wide range of services to its clients, including investment advisory, market research, due diligence, and post-investment support.
http://pandacuads.com/
Investment banking consultant
Email:nolan@pandacuads.com
Cross-border investment in China can be a complex and challenging process, as the country has a unique…
china construction company,china engineering company,china major bridge engineer …
List of Top 500 Chinese Construction Enterprises
ranking
https://gzwatches.cn/
Free engineering construction consultation
Email:nolan@wholsale9.com
Company Name
province
1
China State Construction Corporation Limited
Beijing
2
China Railway Corporation Limited
Beijing
3
China Railway Construction Corporation Limited
Beijing
4
Shanghai Weimengsi Construction Engineering Co., Ltd.
Shanghai
5
China Communications Construction Group Co., Ltd.
Beijing
6
China Power Construction Corporation Limited
Beijing
7
China Energy Construction Group Co., Ltd.
Beijing
8
Shanghai Construction Engineering Group Co., Ltd.
Shanghai
9
Jiangsu Zhongnan Construction Industry Group Co., Ltd.
Jiangsu
10
China Gezhouba Group Co., Ltd.
Hubei
11
China National Chemical Engineering Co., Ltd.
Beijing
12
Sinoma Group Co., Ltd.
Beijing
13
Guangxi Construction Engineering Group Co., Ltd.
Guangxi
14
Shanghai Urban…
Forehead Thermometer Market Analysis (2019- 2025)| Microlife (China), Radiant (C …
This research study is one of the most detailed and accurate ones that solely focus on the global Forehead Thermometer market. It sheds light on critical factors that impact the growth of the global Forehead Thermometer market on several fronts. Market participants can use the report to gain a sound understanding of the competitive landscape and strategies adopted by leading players of the global Forehead Thermometer market. The authors of…
Global Color Steel Tile Market 2017 - South China, East China, Southwest China, …
Color Steel Tile Market Research Report
A market study based on the " Color Steel Tile Market " across the globe, recently added to the repository of Market Research, is titled ‘Global Color Steel Tile Market 2017’. The research report analyses the historical as well as present performance of the worldwide Color Steel Tile industry, and makes predictions on the future status of Color Steel Tile market on the basis…